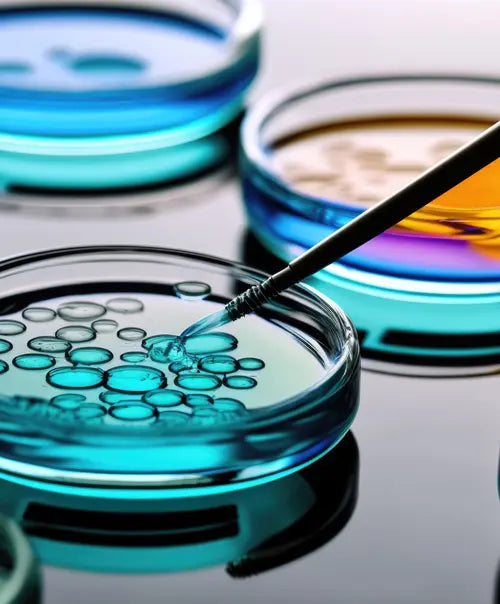

LIP
Ein Sprung nach vorn für Ihre Lippenpflege
Lippenpflege mit echten Strohblumen-Blütenblättern.
Das FLOWER INFUSION LIPPENPFLEGEÖL verleiht den Lippen Glanz mit einem auffüllenden Effekt wie ein Lipgloss und pflegt wie ein Lippenpflegestift. Schenkt intensive Pflege mit einem natürlich glänzenden Finish, in einem hochwertigen Flacon - auch perfekt als Geschenk.
Restrukturierende Haarspülung
Eine Ikone, jetzt mit CERAMIDE-3
Diese Haarspülung sorgt für sofortige Kämmbarkeit, schenkt dem Haar Glanz und macht es geschmeidig. Ceramide pflegen und restrukturieren, für stärkeres und widerstandsfähigeres Haar (auch für behandeltes Haar geeignet).

Für behandeltes &...

...unbehandeltes Haar
Die einzige Phytokosmetik-Marke, die mithilfe der kraftvollen Extrakte der Dolomiten Stress, Smog und Hautalterung entgegenwirkt.

Eine Wissenschaftsgemeinde, die vereint durch die gleiche Berufsethik den Menschen Lösungen für ihre Schönheit und ihr Wohlbefinden bietet.

Innovative, hoch technologische Medizinprodukte und dermatologische Kosmetik mit einer hohen Verträglichkeit.

Der BOOSTER für Ihre Pflegecreme
Bringen Sie Ihre Creme mit nur wenig Tropfen des passenden konzentrierten Aktivstoff auf das nächste Level - auf Basis wissenschaftlicher Forschung.
Alle Aktivstoffe
OSMOTISCHE KÖRPERCREME und GLOBALE ANTI-AGING PFLEGE
Straffende Körpercreme mit globaler Anti-Aging-Wirkung. Samtige und zartschmelzende Textur, ideal für alle Hauttypen.
BELEBENDE AUGENCREME mit WASSERNABEL-EXTRAKT und PEPTIDEN
Ideal für alle Hauttypen. Leichte und schnell einziehende Textur, die ein sofortiges Frischegefühl verleiht und Schwellungen mindert. Spezielle Creme für die Pflege der Augenpartie mit belebender Wirkung. Mildert Augenringe und Tränensäcke und beugt ihrer Entstehung vor.
KONZENTRIERTER AKTIVSTOFF IN TROPFEN
Koffein 5% - Bei Augenschatten und Orangenhaut/Cellulite. Augenpartie: 2 Tropfen des Produkts mit der Creme vermischen, auftragen und einmassieren. Körper: 6-8 Tropfen des Produkts mit der Körpercreme vermischen, auf die betroffenen Stellen auftragen und sorgfältig einmassieren.
KONZENTRIERTER AKTIVSTOFF IN TROPFEN
Vitamin C 20% - Bei Augenschatten und Orangenhaut/Cellulite. Vermischen Sie in Ihrer Handfläche 2-3 Tropfen des Produkts mit Ihrer gewohnten Creme, um die Wirkung zu verstärken.
2
Augenpartie
Zum Beispiel bei Augenschatten 2 Tropfen Koffein 5% mit der belebenden Augencreme vermischen, auftragen und einmassieren.
7
Körper
Gehen Orangenhaut 7 Tropfen Koffein 5% mit der osmotischen Körpercreme vermischen, auf die betroffenen Stellen auftragen und sorgfältig einmassieren.

Über uns
Eine einzigartige und unwiederholbare Geschichte - Es ist die Geschichte einer Freundschaft, einer Intuition und einer Gruppe von Experten, die beschließen ihr Leben und ihre Berufsethik einer authentischen Gemeinschaft zu widmen.
Und so werden seit 40 Jahren wirksame, sichere und erschwingliche Kosmetika, dermatologische Kosmetik, Nutrazeutika und Make-up-Produkte speziell für Apotheken entwickelt.
Über uns
Wissenschaftliche Forschung, Nachhaltigkeit und Fachwissen, damit die Apotheke zu einer Anlaufstelle wird, wo sich unsere Kunden sicher, wohl und gut beraten fühlen.
Unsere Produkte enthalten häufig natürliche Inhaltsstoffe oder pharmazeutische Wirkstoffe, die nachweislich positive Effekte auf die Haut haben.

ANTI-CELLULITE CREME-GEL
Wir liefern innerhalb weniger Tage oft auch am nächsten Tag.
Vergleich
Welche Pflege für Sie geeignet ist?
Sie sind sich nicht sicher, welche Pflege Sie wählen sollen? Wir haben unsere Bestseller ausgewählt. Vergleichen Sie sie und wählen Sie die besten Effekte für Ihre Bedürfnisse.
Mehr erfahren

250 ml
50 ml


Leichte Textur
Premium Pflege für das Gesicht mit osmotischem Fluid
Sie haben Fragen? Wir sind für Sie da.
Sehen Sie sich die häufigsten Fragen unserer Kunden an. Haben Sie weitere Fragen, kontaktieren Sie einfach unseren Kundensupport.
Versenden Sie auch außerhalb von Deutschland?
Aktuell versenden wir unsere Produkte ausschließlich innerhalb Deutschlands. Wir arbeiten jedoch aktiv daran, unseren Versand auch in andere Länder auszuweiten, um Kunden weltweit bedienen zu können.
Die Erweiterung des Versands außerhalb von Deutschland ist ein wichtiger Schritt für uns, der sorgfältig geplant und umgesetzt werden muss, um einen reibungslosen Ablauf und eine zuverlässige Zustellung sicherzustellen.
Wir möchten Sie daher bitten, noch etwas Geduld zu haben.
Falls Sie weitere Fragen haben oder Informationen zu alternativen Versandoptionen benötigen.
Benötige ich ein Konto, um zu bestellen?
Nein, Sie benötigen kein Konto, um eine Bestellung aufzugeben. Wenn Sie jedoch ein Konto einrichten, können Sie z.B. Ihre Versandinformationen speichern oder die Bestellhistorie einsehen. In naher Zukunft wird die Kontoseite um weitere nützliche Funktionen ergänzt.
Wie lang dauert es, bis ich meine Bestellung erhalte?
Die Lieferzeit für Ihre Bestellung beträgt in der Regel 2-3 Werktage. Bitte beachten Sie jedoch, dass es manchmal etwas schneller geht oder in seltenen Fällen etwas länger dauern kann, abhängig von der aktuellen Auslastung unserer Versandpartner.
Wir arbeiten eng mit zuverlässigen Versanddienstleistern zusammen, um sicherzustellen, dass Ihre Bestellung so schnell wie möglich bei Ihnen ankommt.
Wenn Sie weitere Fragen haben oder weitere Informationen zu Ihrer Bestellung benötigen, stehen wir Ihnen jederzeit gerne zur Verfügung.
Bieten Sie Geschenkverpackungen an?
Derzeit bieten wir keine Geschenkverpackungen an. Wir versenden jedoch alle Produkte in unseren schicken Sveea-Design-Versandkartons, die viele unserer Kunden bereits als ansprechende Geschenkverpackung ansehen.
Wir arbeiten daran, diese Option in Zukunft zusätzlich anzubieten.
Wir möchten uns für Ihr Verständnis und Ihre Geduld bedanken. Wenn Sie weitere Fragen haben oder weitere Informationen benötigen, stehen wir Ihnen jederzeit gerne zur Verfügung.
Was sind Ihre Rückgabebedingungen?
Wir möchten Ihnen versichern, dass wir uns im Rahmen der gesetzlichen Bestimmungen zu fairen und transparenten Rückgabebedingungen verpflichtet haben. Als Kunde können Sie sich darauf verlassen, dass Sie Ihr bestelltes Produkt innerhalb der gesetzlichen Rückgabefrist zurücksenden können.
Gemäß den gesetzlichen Vorschriften haben Sie in der Regel ein gesetzliches Widerrufsrecht von 14 Tagen ab Erhalt der Ware. Innerhalb dieser Frist können Sie uns mitteilen, dass Sie von Ihrem Widerrufsrecht Gebrauch machen möchten, und die Ware an uns zurücksenden. Bitte beachten Sie, dass die Rücksendekosten in der Regel von Ihnen als Kunde getragen werden.
Um den Rückgabeprozess so reibungslos wie möglich zu gestalten, können Sie, vor der Rücksendung Kontakt mit unserem Kundenservice aufnehmen. Unser Team wird Ihnen gerne weitere Anweisungen geben und Ihnen bei allen Fragen oder Problemen behilflich sein.
Es ist uns wichtig, dass Sie mit Ihrem Einkauf bei uns zufrieden sind und tun unser Bestes, um Ihnen einen exzellenten Kundenservice zu bieten. Sollten Sie weitere Fragen zu unseren Rückgabebedingungen haben, stehen wir Ihnen gerne zur Verfügung.
Vielen Dank für Ihr Vertrauen und Ihre Unterstützung!
Sonstige Fragen?
Wie kann ich meine Bestellung bezahlen?
Wir akzeptieren verschiedene Zahlungsmethoden, darunter Kreditkarten, Debitkarten, PayPal und Banküberweisungen. Wählen Sie einfach die bevorzugte Zahlungsmethode während des Bestellvorgangs aus.
Gibt es eine Mindestbestellmenge?
Nein, es gibt keine Mindestbestellmenge. Sie können auch einzelne Produkte bestellen, ganz nach Ihren Bedürfnissen und Vorlieben.
Bieten Sie Proben Ihrer Produkte an?
Ja, wir bieten in der Regel Proben unserer Produkte an, die wir gelegentlich zu Ihren Bestellungen mitliefern, damit Sie diese ausprobieren können. Beachten Sie jedoch, dass Proben je nach Verfügbarkeit und Produktangebot variieren können.
Wie kann ich den Kundenservice kontaktieren?
Unser Kundenservice steht Ihnen gerne zur Verfügung. Sie können uns per E-Mail, Telefon oder über das Kontaktformular auf unserer Website erreichen. Wir bemühen uns, Ihnen so schnell wie möglich zu antworten.
Bieten Sie Rabatte oder Sonderaktionen an?
Ja, wir bieten regelmäßig Rabatte und Sonderaktionen an. Halten Sie Ausschau nach unseren Angeboten auf unserer Website oder abonnieren Sie unseren Newsletter, um über aktuelle Aktionen informiert zu werden.
Wie sehe ich den Status meiner Bestellung?
Um den Status Ihrer Bestellung zu überprüfen, loggen Sie sich einfach in Ihr Konto ein und klicken Sie auf "Bestellverlauf".
Nach dem Versand Ihrer Bestellung erhalten Sie eine Versandbestätigung, ggf. mit einer Sendungsverfolgungsnummer. Damit können Sie den aktuellen Status Ihrer Lieferung online verfolgen.
Sind Ihre Produkte für bestimmte Hauttypen geeignet?
Unsere Produkte sind für verschiedene Hauttypen entwickelt worden. Auf den Produktseiten finden Sie detaillierte Informationen zu den Eigenschaften und Anwendungsempfehlungen, um Ihnen bei der Auswahl entsprechend Ihres Hauttyps zu helfen.
Wie lange sind Ihre Produkte haltbar?
Die Haltbarkeit unserer Produkte variiert je nach Produkt und Chargennummer. In der Regel finden Sie auf der Verpackung das Symbol eines geöffneten Cremetiegels mit einer Zahl, die die Haltbarkeitsdauer nach dem Öffnen angibt (z. B. 6M für 6 Monate). Beachten Sie bitte die individuellen Hinweise auf den Produktverpackungen.